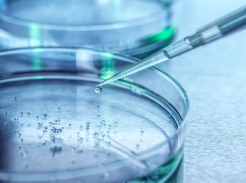
image.png

河南糖尿病干細(xì)胞功效有哪些?治療成功率如何?
2024-11-04 15:15:22 來源: 小編 咨詢醫(yī)生
糖尿病是一種常見的代謝性疾病,全球患者數(shù)量逐年上升。在我國(guó),糖尿病的發(fā)病率也逐年升高,已成為嚴(yán)重影響人們生活質(zhì)量的疾病之一。近年來,干細(xì)胞技術(shù)在治療糖尿病方面取得了顯著成果,尤其是在河南地區(qū)。下面我們來了解一下河南糖尿病干細(xì)胞治療的功效及其治療成功率。
一、河南糖尿病干細(xì)胞治療的功效
1.促進(jìn)胰島β細(xì)胞再生:干細(xì)胞具有多向分化潛能,能夠在體內(nèi)誘導(dǎo)分化為胰島β細(xì)胞,從而增加胰島素的分泌,降低血糖。
2.改善胰島素抵抗:干細(xì)胞治療能夠改善胰島素抵抗,增加胰島素敏感性,降低血糖。
3.促進(jìn)血管新生:干細(xì)胞具有促進(jìn)血管新生的作用,能夠改善糖尿病患者的微循環(huán),降低并發(fā)癥的風(fēng)險(xiǎn)。
4.調(diào)節(jié)免疫平衡:干細(xì)胞具有免疫調(diào)節(jié)作用,能夠降低糖尿病患者的炎癥反應(yīng),減輕胰島β細(xì)胞的損傷。
5.改善代謝功能:干細(xì)胞治療能夠改善糖尿病患者的代謝功能,降低血糖、血脂水平。
二、河南糖尿病干細(xì)胞治療成功率
河南糖尿病干細(xì)胞治療的成功率受到多種因素的影響,如患者年齡、病程、并發(fā)癥等。根據(jù)相關(guān)研究數(shù)據(jù),河南糖尿病干細(xì)胞治療的總有效率在60%-80%之間。具體成功率如下:
1.初發(fā)型糖尿病患者:干細(xì)胞治療成功率較高,可達(dá)80%左右。
2.病程較短的糖尿病患者:干細(xì)胞治療成功率較高,可達(dá)70%左右。
3.病程較長(zhǎng)的糖尿病患者:干細(xì)胞治療成功率相對(duì)較低,約為60%。
4.伴有嚴(yán)重并發(fā)癥的糖尿病患者:干細(xì)胞治療成功率較低,約為50%。
需要注意的是,干細(xì)胞治療糖尿病仍處于研究階段,尚不具備廣泛推廣的條件?;颊咴谶x擇干細(xì)胞治療時(shí),應(yīng)充分了解相關(guān)風(fēng)險(xiǎn)和并發(fā)癥,并在專業(yè)醫(yī)生的指導(dǎo)下進(jìn)行。
總之,河南糖尿病干細(xì)胞治療具有顯著的功效,但成功率受到多種因素影響。隨著干細(xì)胞技術(shù)的不斷發(fā)展,相信未來糖尿病的治療手段將更加豐富,為廣大糖尿病患者帶來更多希望。
-
上一頁(yè): 注射完干細(xì)胞多久能看到效果?效果持續(xù)多久?
- 2024-08-15腸癌干細(xì)胞療法能治愈嗎
- 2024-08-21干細(xì)胞治療小兒自閉癥效果如何,是否值得嘗試
- 2024-09-01蘋果干細(xì)胞的作用原理和實(shí)際運(yùn)用
- 2024-12-03干細(xì)胞療法的藥物配合需注意什么,專業(yè)指導(dǎo)建議來了解
- 2024-08-14干細(xì)胞療法治療疾病靠譜嗎
- 2024-11-08干細(xì)胞療法后會(huì)復(fù)發(fā)嗎,后遺癥有哪些
- 2024-07-19干細(xì)胞填充法令紋,干細(xì)胞填充法令紋后注意事項(xiàng)
- 2024-08-13造血干細(xì)胞采集有什么用
- 2024-10-07造血干細(xì)胞在人體中如何分布?對(duì)健康有哪些影響?
- 2024-10-11 基因干細(xì)胞醫(yī)院排行哪家強(qiáng)?如何選擇正規(guī)機(jī)構(gòu)?
- 2024-09-04干細(xì)胞再生技術(shù)是什么,干細(xì)胞再生修復(fù)多少錢
- 2024-09-20乳牙干細(xì)胞作用是什么,作用原理詳解
- 2024-09-12吉美瑞生干細(xì)胞移植費(fèi)用大概多少錢
- 2024-10-01干細(xì)胞治療胃病需要多少費(fèi)用,與常規(guī)治療相比如何
- 2024-09-13干細(xì)胞的應(yīng)用具體過程與原理詳解
- 2024-10-04干細(xì)胞移植多長(zhǎng)時(shí)間就起作用了
- 2024-08-18造血干細(xì)胞回輸全過程及注意事項(xiàng)
- 2024-09-22胚盤干細(xì)胞存儲(chǔ)機(jī)構(gòu)有哪些,內(nèi)附機(jī)構(gòu)名單
